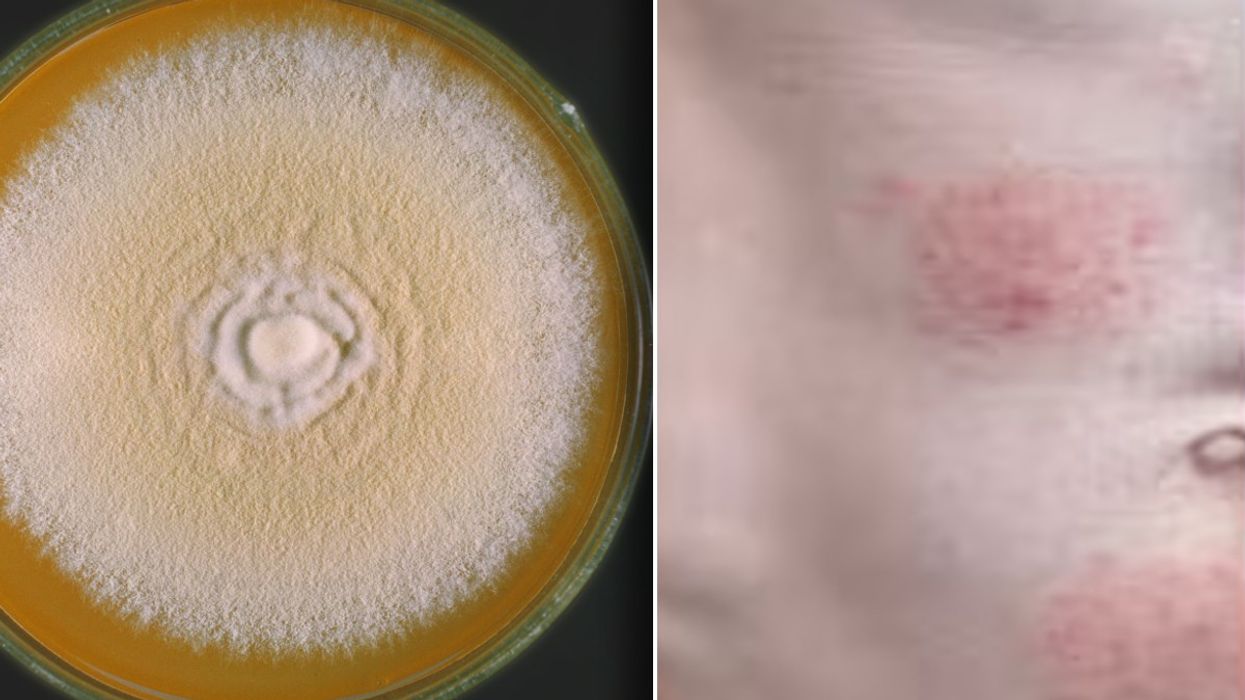

Doctors issue warning over hard-to-treat 'super-fungus' likely to be spreading undetected in Britain​
Doctors issue warning over hard-to-treat 'super-fungus' likely to be spreading undetected in Britain
|GETTY/CDC

The fungus has been described as 'very inflammatory'
Don't Miss
Most Read
Doctors have warned that a hard-to-treat 'super-fungus' is likely spreading undetected across the UK, causing painful rashes that can be transmitted through everyday contact.
The ringworm infection, known as Trichophyton mentagrophytes type VII (TMVII), can spread through hugging, swimming and sexual contact.
Medical experts are particularly concerned as the infection can go undetected for weeks, allowing carriers to unknowingly pass it on to others before realising they are infected.
The infection can initially be mistaken for eczema and may take weeks to properly diagnose, followed by months of treatment.

Trichophyton mentagrophytes fungus
|Getty Images
Dr David Denning, infectious diseases expert at the University of Manchester, explained: "If you had a rash on your chest or your back, you might not bother to deal with it for a week or two."
"If you were to go to a doctor and they prescribe something like a steroid or antibacterial cream but it doesn't work, we could be looking at six to eight weeks since it began."
The infection's ability to spread quickly is particularly concerning, with Dr Denning noting that transmission can occur "in the first two or three weeks to a partner or a friend that you gave a big hug to, went swimming with."
Dr Denning told Mail Online that TMVII is "very inflammatory" with sufferers experiencing a serious rash.
Standard treatments have proven ineffective against the super-fungus, with Dr Denning stating plainly: "Usual treatments don't work."
The infection has already been identified across Asia, the Middle East, North America and France, with concerns that travellers could have brought it to British shores.
Dr Neil Stone, consultant in infectious diseases at University College London Hospitals, warned: "It is inevitably going to spread worldwide including in the UK."

The CDC warns treatment may take 3 months
|CDC
A case in New York has been directly linked to UK travel, with US health officials confirming the patient had previously visited Britain. Additional cases have since emerged in the American city.
The infection can leave permanent scarring in those affected.
Dr Denning issued a stark warning about the fungus's future in Britain, stating: "It will get into the general population of Britain, and we'll end up with it being transmitted in Britain."









